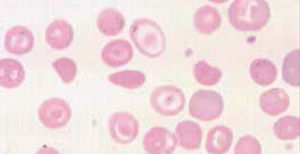
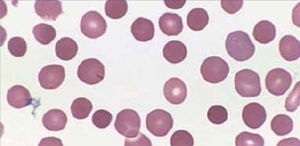
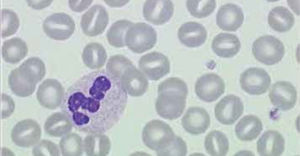
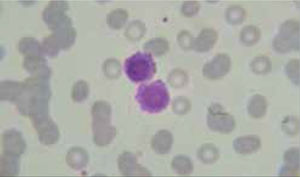
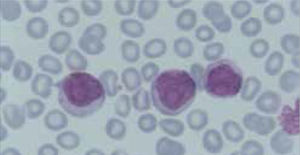
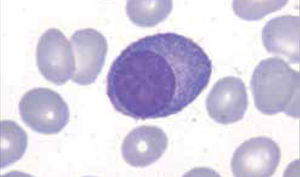

El hemograma es uno de los exámenes de laboratorio solicitado con mayor frecuencia y forma parte del estudio básico requerido para orientación diagnóstica y evaluación de los pacientes.
La vigencia de este examen se ha mantenido desde la introducción de los clásicos índices eritrocitarios descritos por Wintrobe en los años 30, evolucionando con la automatización de los recuentos celulares desarrollada por Coulter en los años 50 y la incorporación de nuevos parámetros como amplitud de distribución eritrocitaria (ADE/RDW) y plaquetaria (ADP/PDW) entregados actualmente por autoanalizadores de última generación.
Los laboratorios de hematología establecen flujogramas o protocolos de validación automática de resultados y de revisión microscópica del frotis de sangre, complementando el uso de equipos de tecnología avanzada, que aportan velocidad de proceso y exactitud en los recuentos celulares, con la tradicional observación microscópica que permite al especialista en hematología reconocer alteraciones morfológicas finas, de relevancia diagnóstica, que no son detectadas por los autoanalizadores.
El objetivo de este artículo es entregar al médico, un enfoque sencillo y práctico para la interpretación del hemograma, recordando algunos conceptos básicos y destacando el aporte de los nuevos índices.
The Cell Blood Count (CBC) is one of the most frequently requested laboratory tests and is part of the basic study required for diagnostic orientation and evaluation of patients.
This test remains valid since the introduction of classic red cell indices described by Wintrobe in the 30s, evolving to automation developed by Coulter cell counts in the 50s and the addition of new parameters such as RDW and PDW (erythrocyte and platelet amplitude distribution) currently delivered by last generation analyzers.
In haematology laboratories it is important to establish flowcharts to complement automatic validation of results that provide speed and accuracy in cell counts, with microscopic review of blood smears, that allows the specialist in hematology recognize fine morphological alterations of diagnostic relevance, which are not detected by the analyzers.
The purpose of this article is to provide the non-specialist, a simple and practical approach to the interpretation of the CBC, recalling some basic concepts and highlighting the contribution of the new indices.
El hemograma es uno de los exámenes solicitado al laboratorio con mayor frecuencia. Interpretado adecuadamente puede orientar la solicitud de exámenes complementarios agilizando el diagnóstico de diversas patologías.
Si el médico no especialista se familiariza con los recuentos celulares normales de la sangre, obtendrá datos prácticos para la evaluación de su paciente.
En las últimas décadas los laboratorios han incorporado autoanalizadores hematológicos que basan su funcionamiento en métodos de alta precisión, entregando recuentos de gran fiabilidad1,2.
La revisión del frotis de sangre al microscopio es cada vez menos frecuente, pero sigue siendo indispensable para detectar alteraciones morfológicas que los autoanalizadores no pueden detectar, por lo que actualmente la mayoría de los laboratorios ha incorporado criterios de revisión del frotis sanguíneo al microscopio3.
El objetivo de este artículo es facilitar al lector no especialista, la interpretación básica de los parámetros entregados en el hemograma, refrescando algunos conceptos fundamentales y señalando también algunos índices disponibles gracias al aporte de las nuevas tecnologías.
HEMOGRAMALas células sanguíneas producidas en la médula ósea pasan a la circulación periférica para cumplir su función.
La sangre periférica constituye el objeto del hemograma, análisis que reúne las mediciones, en valores absolutos y porcentuales y agrega el aspecto morfológico de las tres poblaciones celulares, leucocitos, eritrocitos y plaquetas.
La mayor parte de las alteraciones que encontramos en el hemograma no corresponden a enfermedades que tengan origen en la médula ósea, siendo consecuencia de modificaciones patológicas de diferente naturaleza.
Valores normales o rangos de referenciaExisten múltiples publicaciones con valores de referencia para cada una de las poblaciones celulares del hemograma. Los rangos de referencia deben ser establecidos por cada laboratorio de acuerdo a su propia población normal, considerando sexo y edad. Tabla 14,5.
Valores de referencia de los recuentos celulares
| Hombres | Mujeres | |
|---|---|---|
| Hematíes 106/ml | 5,21 (4,52-5,90) | 4,60 (4,10-5,10) |
| Hemoglobina g/dl | 15,7 (14,0-17,5) | 13,8 (12,3-15,3) |
| Hematocrito (%) | 46 (42-50) | 40 (36-45) |
| Leucocitos 103/ml | 7,8 (4,4-11,3) | |
| Volumen corpuscular medio fl/hematies | 88,0 (80,0-96,1) | |
| Concentración de hemoglobina corpuscular media g/dl | 34,4 (33,4-35,5) | |
| Plaquetas 103/ml | 311 (172-450) | |
Expresados en media y rangos de referencia (rango normal). Dado que las curvas de distribución pueden no ser gaussianas, el rango de referencia es el intervalo de confianza no paramétrico del 95%. Los resultados están basados en 426 adultos normales, y 212 mujeres adultas normales con estudios realizados en un Coulter Modelo S-Plus IV. Esta tabla está pensada como guía. Los rangos de normalidad deben ser validados por los distintos laboratorios clínicos y con sus métodos específicos.
Referencia N° 4.
Los índices eritrocitarios establecidos por Wintrobe en los años 30 indican con precisión cuánto mide un eritrocito promedio, en volumen, peso y concentración de hemoglobina6,7.
VCM (Volumen Corpuscular Medio) Hematocrito x10/Recuento eritrocitos, se expresa en femtolitros(10-15 Fl) y corresponde al promedio del volumen de cada eritrocito. Permite identificar macrocitosis, microcitosis o normocitosis en la muestra. El VCM es un parámetro estable en el tiempo (si el laboratorio recibe muestra de control de un paciente que presenta variación no explicada en su VCM, existe sospecha de confusión de muestra).
HCM (Hemoglobina Corpuscular Media) Hemoglobina x10/Recuento eritrocitos, se expresa en picogramos (10-12 g), representa la carga media de hemoglobina de cada eritrocito. Permite identificar normo e hipocromía.
CHCM (Concentración de Hemoglobina Corpuscular Media) Hemoglobina x100/Hematocrito, se expresa en porcentaje, representa la concentración media de hemoglobina de cada eritrocito.
Los recuentos celulares y hemoglobina pueden ser medidos en forma directa por los autoanalizadores utilizando diferentes métodos como impedancia, difracción de luz, láser y otros, y sus sistemas de cálculo integrado permiten obtener los índices eritrocitarios en forma automática8.
La alteración más frecuente que se encuentra al interpretar un hemograma es la anemia. El uso de los índices eritrocitarios VCM (tamaño) y CHCM (cromía), combinado con el recuento reticulocitario, permite orientar la búsqueda etiológica, clasificando la anemia como: normocítica-normocrómica, microcítica–hipocrómica, macrocítica, regenerativa o arregenerativa.
ANEMIASe define por la concentración de hemoglobina, que debe ser menor a la establecida como normal para la edad y sexo del paciente. El hematocrito es un parámetro calculado por los equipos automatizados por lo que no se utiliza en la definición de anemia. El recuento eritrocitario no se correlaciona con la cantidad de hemoglobina, pues depende del tamaño eritrocitario.
Anemia MicrocíticaHallazgo de anemia con presencia de eritrocitos de tamaño inferior a lo normal (VCM disminuido), generalmente asociada a hipocromía (HCM, CHCM disminuidas). La causa más frecuente en nuestro medio de anemia microcítica hipocrómica es la ferropenia, cuya confirmación la entregará la historia clínica del paciente y el estudio de Fe (cinética de Fe y ferritina). Figura 1.
La presencia de un rasgo talasémico (Talasemia menor) también se presenta habitualmente en el hemograma como anemia microcítica hipocrómica, en este caso el VCM es habitualmente cercano a 60fl y los hallazgos morfológicos en la observación del frotis sanguíneo al microscopio orientan al diagnóstico: se pueden apreciar diferentes formas de eritrocitos con células en diana o targets cells y presencia de punteado basófilo grueso. Los reticulocitos están elevados por hemólisis, visualizándose al frotis como policromatofilia. El diagnóstico de certeza de esta condición se realiza por electroforesis de hemoglobina.
El índice de Mentzer (VCM/Recuento de eritrocitos) era usado antiguamente como orientación diagnóstica para diferenciar estas dos condiciones. Un índice de Mentzer menor a 13 es sugerente de Talasemia y si es mayor a 13 sugerente de ferropenia. En la actualidad este índice ha sido en parte reemplazado por un nuevo parámetro entregado automáticamente por algunos contadores hematológicos de ultima generación: razón %microcitosis %hipocromía, donde un ratio > 0.9% sugiere Talasemia18,19.
La presencia de anemia microcítica (con frecuencia hipocroma), puede verse también en las etapas más avanzadas de las denominadas enfermedades inflamatorias crónicas, en las cuales el fierro se distribuye en forma anómala por citocinas propias de estos procesos (TNF alfa, interleucinas), siendo desplazado al sistema mononuclear fagocítico en lugar de ser utilizado en la hematopoyesis. La hepcidina juega también un rol relevante en la disponibilidad del Fe. El cuadro clínico del paciente asociado al estudio de fierro (TIBC normal o disminuida con ferritina normal o elevada) debe orientar a lo que habitualmente se denomina como anemia de las enfermedades crónicas9,10.
Anemia MacrocíticaHallazgo de hemoglobina bajo el rango normal con presencia de eritrocitos de tamaño mayor a lo normal (VCM elevado). Con mayor frecuencia es provocada por déficits en vitamina B12 o ácido fólico que son esenciales para la síntesis de DNA y reproducción celular, afectando a los eritrocitos, pero también a las otras poblaciones celulares. Los síndromes mielodisplásicos suelen presentarse con anemia macrocítica porque generan eritropoyesis ineficaz, anemia que está acompañada generalmente de citopenias y alteraciones morfológicas en las otras series.
Otras causas de anemia macrocítica son las anemias secundarias a hepatopatías crónicas, pacientes gastrectomizados, tratamientos con fármacos que afectan el metabolismo del ácido fólico y anemias regenerativas como es el caso de anemias hemolíticas que presentan aumento de glóbulos rojos jóvenes (reticulocitos) que tienen un volumen más alto que los eritrocitos maduros.
Anemia Normocítica NormocrómicaSe observa disminución de la hemoglobina y hematocrito, sin alteración de los índices eritrocitarios. Puede originarse por diversas causas, algunas hematológicas como hipoplasia y aplasia medular11, o etapas iniciales de anemia por sangrado (previo a la producción de ferropenia) y también causas no hematológicas como la anemia de insuficiencia renal crónica por déficit de eritropoyetina. La anemia secundaria a cuadros inflamatorios crónicos en sus etapas iniciales también puede presentarse con normocitosis y normocromía.
RETICULOCITOSEl recuento de reticulocitos mide la producción de glóbulos rojos. Los reticulocitos corresponden a los glóbulos rojos jóvenes con RNA residual. El RNA tiene afinidad por los colorantes básicos de la tinción May Grunwald Giemsa, utilizada para la evaluación del frotis al microscopio, es esta afinidad la que da a los reticulocitos el característico color gris azulado que se denomina policromatofilia. El recuento no automatizado de reticulocitos se realiza en un frotis teñido con tinción de Azul Cresil brillante.
El recuento automático de reticulocitos basado en citometría de flujo con colorantes específicos que se enlazan al RNA, es entregado por los autoanalizadores como recuento absoluto y porcentaje y ha sido incorporado en muchos laboratorios por su menor variabilidad inter observador y por disminuir el tiempo de informe del hemograma.
El recuento de reticulocitos aumentado o disminuido, permite clasificar a las anemias en regenerativas y arregenerativas (recuento absoluto menor a 50.000/mm3), constituyendo otra herramienta de gran utilidad para orientar el diagnóstico de anemia. Se observa recuento disminuido o ausencia de reticulocitos en anemias por falla medular (aplasia, infiltración), y recuento de reticulocitos elevados asociado a las anemias secundarias a destrucción periférica (hemólisis). (Figura 2).
ERITROCITOSPoliglobulia, policitemiaAumento del recuento de eritrocitos sobre el valor normal.Antes de considerar una patología hematológica, es relevante para el médico no especialista, reconocer algunas causas de pseudopoliglobulias o policitemias relativas tales como: hemoconcentración (deshidratación severa, quemaduras), hipoxemia crónica (secundaria a enfermedad respiratoria, patología cardiovascular o tabaquismo) y especialmente el efecto de altura (procedencia de países altiplánicos, desempeño en faenas mineras, entre otros).
La poliglobulia absoluta propia de la Policitemia Vera, se acompaña de otras alteraciones en el hemograma características de un síndrome mieloproliferativo, tales como leucocitosis y trombocitosis. Al examen físico del paciente es frecuente encontrar esplenomegalia. Estos pacientes requieren estudio especializado.
Alteraciones morfológicas de los eritrocitosEn la observación del frotis de sangre al microscopio se reconocen alteraciones en la morfología de los eritrocitos que no son detectadas por los autoanalizadores, algunas de ellas son relevantes para orientar al diagnóstico de ciertas patologías, por ejemplo: la presencia de esquistocitos (glóbulos rojos fragmentados) es un signo de las anemias hemolíticas microangiopáticas, la presencia de megalocitos con inclusiones citoplasmáticas (anillos de Cabot, cuerpos de Howell Jolly) es frecuente en las anemias megaloblásticas, los dacriocitos (glóbulos rojos en forma de lágrima) son característicos de la mielofibrosis, los microesferocitos (glóbulos rojos pequeños y esféricos) son propios de la anemia hemolítica congénita microesferocítica. Tabla 212.
Alteraciones morfológicas de los eritrocitos
| Nomenclatura | Cuadros Hematológicos | Imagen | |
|---|---|---|---|
| Consenso | Equivalente | ||
| Acantocitos | Espinoso, en espuela espiculado | Anemia hemolítica microangiopática, hepatopatías alcohólicas, acantocitosis hereditarias, abetalipoproteinemia | |
| Codocitos | Dianocitos, target cell | Hepatopatía obstructiva, Hb SS, CS, talasemia | |
| Queratocitos | Células en casco | PTT, CID, síndrome urémico hemolítico, anemia hemolítica microangiopática | |
| Dacriocitos | Células en lágrimas | Mielofibrosis, eritropoyesis ineficaz, talasemia, anemia megaloblástica | |
| Drepanocitos | Falciformes,sickle cell | Anemia falciforme, Hb CS, HB S -tal | |
| Eliptocitos | Eliciptosis hereditaria, ferropenia, talasemia | ||
| Nomenclatura | Cuadros Hematológicos | Imagen | |
|---|---|---|---|
| Consenso | Equivalente | ||
| Ovalocitos | Anemia megaloblástica | ||
| Esquistocitos | Esquizocitos | Anemia hemolítica microangiopática, hemólisis de fragmentación | |
| Equinocito | Crenocitos | Insuficiencia renal, déficit de piruvatoquinasa, artefacto | |
| Esferocitos | Esferocitosis hereditaria, anemia hemolítica TCD+, hemólisis de fragmentación | ||
| Estomatocitos | Estomatocitosis hereditaria, hepatopatía obstructiva, alcoholismo, cirrosis, artificio | ||
| Megalocitos | Macroovalocitosis | Anemia megaloblástica | |
Modificada de Referencia N° 12.
Constituyen una población celular heterogénea, sus características morfológicas y funcionales permiten su diferenciación y es en base a estas características que los autoanalizadores de última generación son capaces de realizar recuentos de algunas poblaciones leucocitarias semejantes a los obtenidos por la lectura del frotis al microscopio.
Al interpretar un hemograma, el médico no especialista está más habituado al uso de los porcentajes informados para cada una de las poblaciones leucocitarias que al valor absoluto de las mismas, que corresponde a la unidad de volumen (microlitro o litro). Considerar solamente los porcentajes de los diferentes leucocitos puede conducir a errores de interpretación. Si utilizamos como ejemplo los neutrófilos; no es igual 50% de neutrófilos en un recuento total de 10.000 leucocitos por mm3, que 50% de neutrófilos en un recuento total de 1.000 leucocitos. En el primer caso el recuento absoluto de neutrófilos es normal (5.000) y en el segundo caso hay una situación de neutropenia crítica (500) que requiere aviso e intervención de inmediato.
De la misma forma, considerando el valor absoluto de la población linfocitaria es posible diferenciar linfocitosis relativa de linfocitosis absoluta. Con frecuencia vemos en el laboratorio que no se identifica en forma oportuna una condición de neutropenia o que solicitan exámenes complementarios para estudio de linfocitosis, al interpretar como linfocitosis absoluta una linfocitosis que es relativa.
Otra forma válida de hacer la interpretación correcta es utilizar el porcentaje de una determinada población leucocitaria, con la cifra total de leucocitos. Ej.: 60% de linfocitos con 20.000 leucocitos totales.
Los autoanalizadores de última generación han incorporado nueva metodología para diferenciar las principales poblaciones leucocitarias, sin embargo la observación del frotis sanguíneo al microscopio sigue siendo indispensable para evaluar aspectos morfológicos específicos de los leucocitos que no son detectados por los equipos automatizados y que son relevantes para algunos diagnósticos, tales como: aspecto de la cromatina nuclear, presencia de nucléolos, inclusiones citoplasmáticas, hemoparásitos, cambios displásticos, etc.
Los autoanalizadores también presentan limitaciones para diferenciar la presencia en la sangre periférica de células propias de patologías hematológicas como: blastos, células inmaduras, prolinfocitos, linfocitos atípicos, células velludas, células plasmáticas, células de Sezary y otras, que deben ser reportadas de inmediato por el laboratorio al médico tratante. Tabla 3.
La descripción morfológica entregada por el laboratorio es relevante para el clínico, en particular la descripción de células inmaduras o blastos, condición que requiere ser evaluada a la brevedad por el especialista, para descartar leucemias agudas.
Se recomienda que cada laboratorio hematológico establezca sus propios criterios de revisión de láminas de acuerdo a la población de pacientes que atiende13.
NeutrofiliaAumento en el recuento absoluto de neutrófilos (neutrófilos >8.000/ml), se observa con mayor frecuencia en procesos infecciosos bacterianos, puede acompañarse de aumento en la sangre periférica de formas menos maduras de leucocitos, como baciliformes y mielocitos, hallazgo más conocido como desviación a izquierda, si la cifra de leucocitos es más elevada y se observan células inmaduras en el frotis se denomina reacción leucemoide.
Se puede observar neutrofilia en cuadros inflamatorios no infecciosos como colagenopatías, en condiciones de estrés, ejercicio intenso, hipoxia y asociada al uso de algunos medicamentos como corticoides, adrenalina, entre otros.
La neutrofilia propia de patologías hematológicas como Síndromes Mieloproliferativos crónicos se acompaña de alteración en los recuentos de las otras series celulares y características morfológicas especiales.
NeutropeniaDisminución en el recuento absoluto de neutrófilos (RAN <1.500/ml), la causa más frecuente es la inducida por fármacos, de una lista muy extensa cabe destacar quimioterápicos, antiinflamatorios no esteroidales, antiepilépticos, psicofármacos. En algunas infecciones virales como hepatitis, influenza, HIV y también en sepsis graves se pueden observar neutropenias severas. El parámetro RAN (recuento absoluto de neutrófilos), ha sido incorporado de rutina en el hemograma, permitiendo visualizar de inmediato la condición de neutropenia. Se considera neutropenia severa un RAN < 500 x mm3.
Otras alteraciones en la fórmula diferencial de los leucocitos14Eosinofilia: Aumento en el recuento absoluto de eosinófilos, (eosinófilos >800/ml). Alergias, parasitosis y algunos fármacos son sus causas más frecuentes.
Linfocitosis: Aumento en el recuento absoluto de linfocitos, (linfocitos >4000/ml). Con mayor frecuencia es producida por infecciones virales.
Monocitosis: Aumento en el recuento absoluto de monocitos, (monocitos>1000/ml). Es característica en el período de recuperación de neutropenias y en convalecencia de cuadros infecciosos.
PLAQUETASLa automatización de los recuentos hematológicos ha permitido incorporar el recuento plaquetario en forma habitual al informe del hemograma. El pequeño volumen de las plaquetas y su capacidad de agregación y adhesión representó por años una limitante para su recuento en cámara, de modo que la forma más frecuente utilizada para informar el recuento plaquetario consistía en una apreciación directa al frotis, lo que requería excelencia en la técnica de extensión y tinción del frotis y gran experiencia del observador.
Con el perfeccionamiento de los sistemas automáticos de recuento, que incluyen impedancia y lectura óptica mediante láser (incluyendo algunos equipos la posibilidad de agregar método inmunológico para reconocer marcador CD61), se obtienen recuentos plaquetarios rápidos y confiables. Los índices plaquetarios desarrollados son cada vez más utilizados por los especialistas.
TrombocitopeniaEs la disminución del recuento plaquetario bajo el rango de referencia establecido por el laboratorio (recuento plaquetario <100 x109/l).
Puede ser originada por diversos mecanismos:
- -
Inmunológico: por presencia de anticuerpos, como es el caso del Púrpura Trombocitopénico Inmune, lupus eritematoso sistémico, síndrome de Evans, síndrome antifosfolípido y trombopenia isoinmune neonatal, entre otras patologías.
- -
Trombopoyesis ineficaz: se observa en la anemia perniciosa, mieloptisis, mielodisplasias, hemoglobinuria paroxística nocturna, radiación, drogas antineoplásicas, entre otros.
- -
Destrucción no inmune, sobreconsumo: se observa en sepsis, CID, hemangioma cavernoso, infección por HIV.
- -
Distribución anormal o secuestro: en hiperesplenismos de cualquier origen.
El hallazgo de un recuento bajo de plaquetas, no sospechado e inesperado para el cuadro clínico del paciente, puede corresponder a una pseudotrombocitopenia. Algunos ejemplos de esta condición son: las punciones venosas difíciles (en niños pequeños, ancianos) que pueden originar activación plaquetaria con formación de microcoágulos, la agitación insuficiente del tubo para mezclar la muestra de sangre con el anticoagulante es otra causa de micro coágulos.
También produce un recuento falsamente disminuido el efecto de agregación plaquetaria «in vitro» provocado por el anticoagulante EDTA, mediante activación de anticuerpos antifosfolípidos. Este efecto se reconoce fácilmente por la observación de las plaquetas agregadas al frotis y el laboratorio sugiere en estos casos análisis de una nueva muestra obtenida con otro anticoagulante como citrato o ACD.
TrombocitosisCorresponde a recuento de plaquetas mayor al rango de referencia establecido por el laboratorio (recuento plaquetario >400 x 109/l), se puede observar en diferentes patologías como: cuadros inflamatorios crónicos, recuperación de procesos infecciosos, hemorragia aguda, déficit de fierro, post esplenectomía, entre otros.
Trombocitosis con alza progresiva y sostenida en el recuento plaquetario se asocia a síndromes mieloproliferativos crónicos: leucemia mieloide crónica, policitemia vera, mielofibrosis y especialmente a trombocitosis esencial.
NUEVOS ÍNDICESLos contadores hematológicos de última generación han desarrollado índices que el laboratorio de hematología ha incorporado en su rutina, si bien la mayor parte de los laboratorios no los incluye en el informe final del hemograma, conocerlos puede ser de utilidad para una mejor interpretación del resultado15,16.
RDW (Red Blood Cell Distribution Widht): Se expresa en porcentaje, representa el coeficiente de variación de tamaño de los eritrocitos, amplitud de la distribución eritrocitaria (ADE) que es reflejo de la anisocitosis o diferencia de tamaño de los glóbulos rojos. Figura 3.
Amplitud de distribución de hematíes
Contador hematológico Advia 2120i. Siemens. Las muestras normales tienen una distribución en forma de campana con un canal modal de entre 60 fl y 120 fl. El volumen corpuscular medio (VCM) y la amplitud de distribución de hematíes (IDH) se determinan a partir de este histograma. El VCM es la media del histograma Volumen HEM. La IDH es el coeficiente de variación de la población. El factor de calibración VCM se ha aplicado a los datos mostrados.
En el hemograma normal siempre existe un grado de anisocitosis, los glóbulos rojos más jóvenes tienen un volumen mayor que los glóbulos rojos más maduros, es así como el RDW permite observar de manera gráfica cuando coexisten en una muestra dos poblaciones eritrocitarias de diferentes tamaños (por ejemplo: en el caso de un paciente con anemia microcítica hipocrómica que ha recibido transfusión reciente, o el caso de paciente con anemia hemolítica con presencia de microesferocitos y reticulocitos elevados). Así también se pueden observar modificaciones en la RDW en el contexto evolutivo de una anemia en tratamiento.
PDW: Es el equivalente del RDW para las plaquetas (amplitud de distribución plaquetaria ADP). Figura 4.
Histograma de volumen de plaquetas
Contador hematológico Advia 2120i. Siemens. El histograma vol plaquetas del análisis de plaquetas bidimensional muestra la distribución de las células según el volumen. Los datos de volumen se obtienen del análisis integrado.
El histograma tiene un rango de 0 fl a 60 fl. Las plaquetas grandes con volúmenes de hasta 60 fl se incluyen en el contaje PLQ.
VPM: Volumen plaquetario. Analizar en conjunto ambos índices (PDW–VPM) es útil en el estudio de una trombocitopenia, si ambos índices se encuentran elevados sugiere una destrucción periférica de plaquetas, como es el caso del hiperesplenismo y del púrpura trombocitopénico inmune. Las plaquetas más jóvenes son de mayor tamaño que las plaquetas adultas.
Por otra parte un PDW normal con VPM bajo sería el patrón asociado a una baja producción medular como es el caso de infiltración medular o mielosupresión17.
Razón: %microcitosis/ %hipocromía: Ratio entregado por algunos autoanalizadores de última generación, por medición directa del volumen y la concentración de hemoglobina de los eritrocitos se mide el porcentaje de eritrocitos microcíticos y macrocíticos, y de eritrocitos hipocromos e hipercromos entregando una razón o ratio. Si el ratio es mayor a 0.9% orienta hacia el diagnóstico de talasemia y menor de 0,9% orienta a ferropenia18,19.
CHR o Ret-He: Contenido de hemoglobina de los reticulocitos, refleja la síntesis de hemoglobina en precursores medulares, se correlaciona con el porcentaje de eritrocitos hipocromos y ha demostrado utilidad en el seguimiento de déficit de Fierro, puede ser empleado para el diagnóstico precoz de ferropenia. Por su alta sensibilidad para detectar requerimiento de Fierro ha sido utilizado en pacientes en hemodiálisis, para controlar el tratamiento con eritropoyetina.
FIR: Fracción inmadura de reticulocitos. Es la suma de las fracciones de contenido alto y medio del RNA. Clínicamente es útil como índice precoz y sensible de la actividad eritropoyética. Un recuento de reticulocitos bajo con un FIR elevado sugiere recuperación medular20,21.
OTRAS CONDICIONES QUE AFECTAN LOS RECUENTOS HEMATOLÓGICOSAl interpretar los resultados informados en el hemograma el clínico debe tener en consideración algunas condiciones propias de su paciente que pueden afectar los recuentos celulares. Estas condiciones habitualmente no son informadas al laboratorio:
Muestra diluida: Muestra de sangre obtenida directamente de vías venosas y/o en sitio cercano a infusión de suero. La hemodilución afecta a todos los recuentos, disminuyendo hematocrito, leucocitos y plaquetas, conservando las características morfológicas, los índices eritrocitarios y la fórmula diferencial.
Trabajo (permanencia) en altura – Tabaquismo severo: Aumenta el recuento de eritrocitos. Poliglobulia secundaria.
Ejercicio intenso: Puede ser causa de leucocitosis y neutrofilia.
Efecto de medicamentos:Con frecuencia el paciente olvida mencionar fármacos de uso permanente (generalmente asociados a patologías crónicas) en la información que entrega en el laboratorio.
Muchos fármacos alteran los recuentos celulares, si este efecto no es conocido por el médico que solicitó el examen, un resultado esperable para la condición del paciente, puede confundir e inducir a solicitar exámenes complementarios innecesarios.
En el laboratorio se obtienen a diario resultados fuera de rango de referencia por efecto de medicamentos, a modo de ejemplo cabe mencionar el efecto de:
- -
Corticoesteroides: aumento de leucocitos (neutrofilia) y ausencia de eosinófilos.
- -
Litio: leucocitosis (neutrofilia).
- -
Antiinflamatorios no esteroidales: leucopenia, neutropenia.
- -
Ácido Valproico: trombocitopenia.
- -
Inmunosupresores (Azathioprina, Methotrexate): anemia macrocítica, pancitopenia.
- -
Isotrenitoína: pancitopenia.
- -
Tratamientos quimioterápicos: la quimioterapia es un antecedente habitualmente reportado al laboratorio por el médico o el paciente. Sin embargo, el uso de factores estimulantes de la médula ósea asociado a la quimioterapia, que provoca leucocitosis intensa y reacciones de tipo leucemoide, no es informado al laboratorio, generando alarmas de revisión, reprocesamiento de la muestra y solicitud de nueva muestra.
Es el tiempo que tardan en decantar los eritrocitos en una columna de sangre de un volumen determinado. Técnica publicada por Westergreen en 1926, mide la longitud de la columna de sangre anticoagulada con citrato, que queda libre de eritrocitos luego de una hora de permanecer en posición vertical.
La VHS depende: del potencial z (potencial electrostático negativo de la membrana de los eritrocitos que lleva a los eritrocitos a repelerse entre sí), del recuento de eritrocitos, de la viscosidad del plasma, las proteínas plasmáticas, fibrinógeno, entre otros.
Los reactantes de fase aguda de la inflamación modifican el potencial z de los eritrocitos aumentando la VHS.
En el último tiempo se ha discutido la utilidad de este examen por su baja especificidad, ya que puede verse afectada por una gran cantidad de condiciones, incluso fisiológicas como edad, sexo y embarazo. Se observa aumento moderado de la VHS asociado a patologías infecciosas, anemia, cuadros inflamatorios, neoplasias, etc.
Sin embargo, cuando la VHS está elevada por sobre 100mm/h, adquiere alta especificidad y es útil en diagnóstico y seguimiento de patologías como: mieloma múltiple, enfermedad de Waldestrom, cáncer metastásico, colagenopatías (polimialgia reumática y arteritis temporal) y linfomas.
Por ser una técnica simple y de bajo costo, la VHS ha mantenido su vigencia, considerándose una herramienta práctica para el clínico, como un indicador de amplio espectro de enfermedad.
COMENTARIO FINALNo está de más recordar que para garantizar la utilidad clínica del hemograma, los laboratorios clínicos deben velar por la calidad analítica de los resultados, mientras los médicos deben poner su esfuerzo en la mejor interpretación posible a la luz del contexto clínico de cada paciente.
La autora declara no tener conflictos de interés, en relación a este artículo.